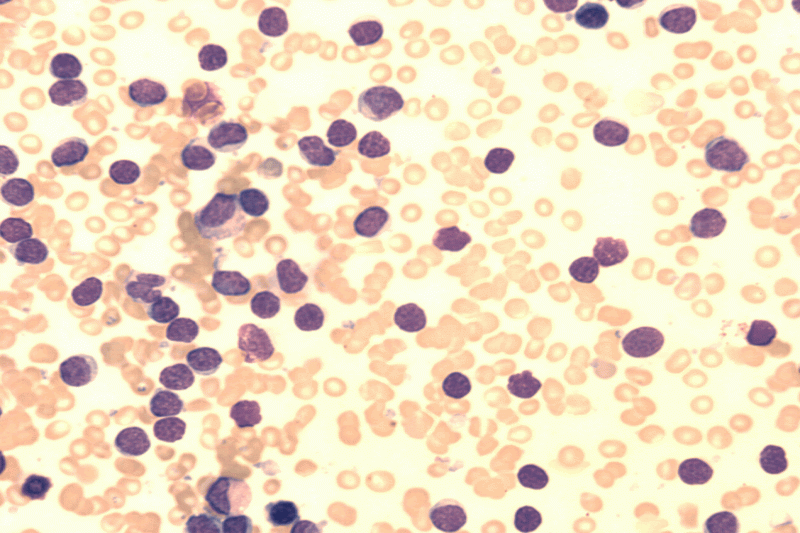
Лейкемия

Кошачьи вирусные инфекции довольно многочисленны и разнообразны. И даже если ваш питомец никогда не выходит на улицу, он все равно рискует заболеть. Вирус можно принести в дом на обуви. А если вы возите усатого любимца на дачу, то этот риск возрастает в несколько раз.
Вирус бешенства (Rabies lyssavirus)
К бешенству восприимчивы все животные, а также человек. В этом и кроется его главная опасность, ведь в короткие сроки оно способно не только привести к летальному исходу, но и успеть распространиться на другие живые организмы.

Переносчики – заболевшие животные (в том числе дикие). Заболевание нередко протекает в скрытой форме от 7 дней до нескольких месяцев.
Наиболее частые симптомы:
вялость, резко сменяющаяся приступами ласки, а потом агрессии;
снижение аппетита;
повышенная раздражительность и боязливость;
агрессия в ответ на яркое освещение и громкий шум, кот царапается и кусается;
поедание несъедобных вещей;
невозможность проглотить воду;
слюнотечение;
паралич конечностей, нервной и дыхательной систем.
Эффективного лечения не существует. Чтобы не допустить массового распространения, по закону каждый хозяин обязан ежегодно прививать своего четвероногого друга (применяется Vaccine Rabies). И только при помощи такой профилактики удастся обезопасить его и себя.
Кальцивироз, или кальцивирусная инфекция (FCV)

О кальцивирозе свидетельствуют повышенная температура тела и поражение органов дыхания. По статистике чаще болеют животные в молодом возрасте и в зимний период. Из-за схожих симптомов легко спутать с ринотрахеитом. Наблюдаются:
потеря аппетита, снижение веса;
побледнение слизистых оболочек;
быстрая утомляемость и слабость;
выделение слизи из глаз и носа;
пузырьки и язвы на языке и ноздрях.
Ко всему прочему могут «подключиться» иные сложные недуги дыхательной системы (бронхит, пневмония и др.).
Кальцивироз лечится, но очень трудно. Врач назначает лекарства, купирующие воспаления в дыхательных путях. Проще этого избежать благодаря вакцинации.
Инфекционный, или герпесвирусный, ринотрахеит (FHV)
Герпесвирус поражает глаза и дыхательные пути. Заболевают представители кошачьих любых пород и всех возрастов. Выздоровевшие особи получают иммунитет.
.jpg)
Вредоносный неклеточный агент из семейства Herpesviridae способен долго жить в организме, никак не проявляя себя.
Острая форма характеризуется:
повышением температуры тела до 40 градусов;
гнойными выделениями из глаз и носовой полости;
слюнотечением;
кашлем, сильными хрипами;
отечностью носа и глотки.
Кроме того, велика вероятность осложнений в виде бронхита, пневмонии и язв на коже.
Больных кормят жидкой или полужидкой пищей. Врач обычно назначает иммуностимуляторы, противовирусные препараты, витамины С и группы В. Вылечить недуг сложно, поэтому рекомендуется проводить ежегодные прививки от вирусного ринотрахеита кошек.
Короновирусные инфекции

Короновирусы вызывают два кошачьих заболевания:
- Инфекционный перитонит, или ФИП (Feline Infectious Peritonitis) – почти во всех случаях приводит к смерти. В группе риска – чистопородные коты со слабым иммунитетом. О перитоните свидетельствуют: малокровие, диарея, рвота, лихорадка, затрудненность дыхания, вздутие живота, уплотненность кишечника. Болезнь зачастую маскируется под другие менее опасные.
- Коронавирусный энтерит (FCov) – чаще возникает у котят, сопровождается диареей, рвотой, лихорадкой и, как правило, неопасен для жизни.
К сожалению, эффективных вакцин пока не разработали, так как короновирусы бывают разных типов. Не все из них представляют серьезную опасность, но при этом многие быстро мутируют и становятся смертельными. В качестве профилактической меры проводят дезинфекцию помещений при помощи нашатырного спирта.
Панлейкопения, или чума кошек (FPV)
Заболевание провоцирует парвовирус, который особенно активен с ранней весны до поздней осени. Инкубационный период длится до недели, после чего панлейкопения характеризуется такими признаками, как:
повышенная температура (до 41 градуса);
любые нарушения со стороны ЖКТ;
истечения из глаз и носа;
сбой в работе сердца и сосудов.

Котята умирают от этой заразы примерно в 90 процентах случаев. Лечение от панлейкопении назначает ветврач. Хозяин должен внимательно следить за питанием больного. Важна специальная диета с 5-7 приемами пищи в день. Единственный эффективный метод борьбы – ежегодная вакцинация.
Болезнь Ауески, или псевдобешенство

Инфекционному агенту Herpes suis, приводящему к этому недугу, подвержены грызуны и домашние животных разных видов, в том числе свиньи, собаки, коровы, овцы. Так, усатый любимец рискует заразиться при поедании больной мыши. В первую очередь страдают кожа и центральная нервная система. Организм быстро погибает от воспаления мозга. Также вероятны:
слюнотечение;
рвота;
сильное желание пить;
зуд по всему телу;
все симптомы бешенства.
Лечение возможно только на ранней стадии, однако редко приводит к позитивному исходу. Поскольку болезнь Ауески часто путают с бешенством, многих животных и вовсе сразу усыпляют.
Лейкемия, или FeLV (Feline Leukemia Virus)
Вирус лейкоза сильно ослабляет иммунитет и провоцирует появление раковых новообразований (например, лимфосаркомы). Это быстро приводит к смерти. Признаки лейкоза сильно варьируются и маскируются под иные заразы.
Важно оберегать питомца от контакта с незнакомыми котами и своевременно вакцинировать (хотя, к сожалению, современная вакцина не дает гарантий). Самый рациональный выход из ситуации – сразу же делать анализ каждому питомцу, которого вы берете под свою опеку.
Однако нужно понимать, что вирус лейкемии сродни ВИЧ: если он диагностируется, еще не значит, что организм болен. Зараза не передается человеку, поэтому при отсутствии симптомов необходимо лишь оберегать питомца от любых других хворей (в том числе бактериальных, грибковых) и не давать контактировать с котами, чтобы не заразить их.
К счастью, в некоторых случаях иммунитет усатого любимца способен сам справиться с FeLV. Поэтому будет не лишним каждые несколько месяцев повторять обследования в надежде, что результат будет отрицательным.
Вирус иммунодефицита кошек, или FIV (Feline Immunodeficiency Virus)
Кошачий иммунодефицит – то же самое, что ВИЧ. Он может спровоцировать развитие каких-либо недугов (от неопасного лишая до онкологии). Вакцин и лекарств от него нет, поэтому остается только периодически сдавать анализы (начиная с возраста старше полугода) и оберегать своего любимца от общения с незнакомыми сородичами.

Как и в случае с FeLV, положительный результат анализа еще не свидетельствует о заболевании. Известны случаи, когда коты с FIV прекрасно жили около 10 лет. Просто им нужно больше внимания хозяина, который в тандеме с ветеринаром будет своевременно побеждать любые недуги, атакующие и без того ослабленный организм четвероногого друга.
И учтите: FIV передается внутриутробно от матери котятам. Поэтому носителей не используют в разведении.
Все эти кошачьи вирусные инфекции (кроме бешенства) не передаются человеку, но опасны для жизни больного. Каждый год делайте комплексные прививки, внимательно наблюдайте за поведением питомца и при первых же недомоганиях не занимайтесь самолечением, а отвезите его в ветеринарную клинику для проведения лабораторных исследований и постановки правильного диагноза.
Выбор языка


.jpg)
.jpg)
.jpg)
.png)